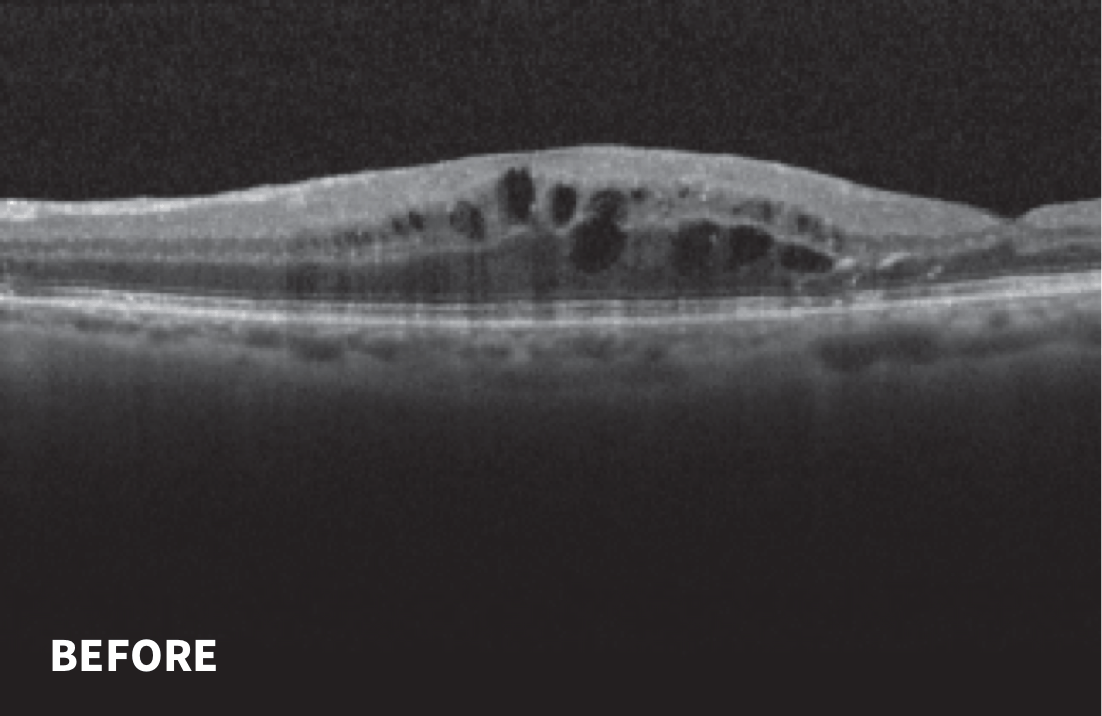
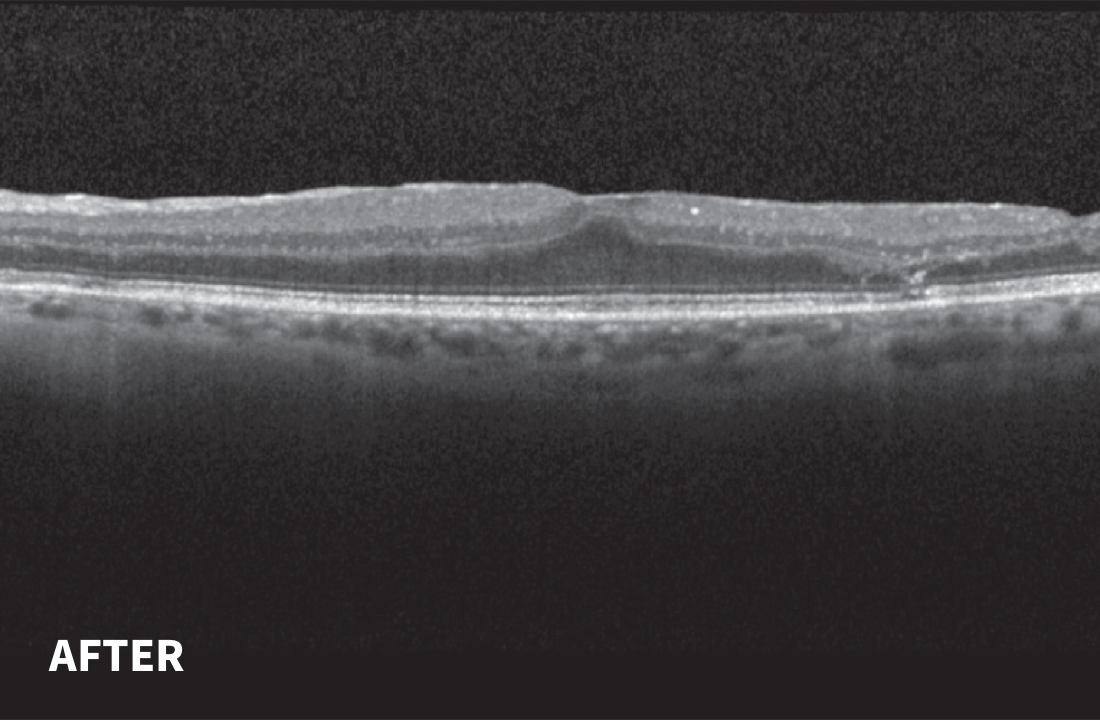

![]()
Initial Presentation
Patient demographics
70-year-old white male
Relevant medical history
History of PPV OS for symptomatic vitreous opacities, subsequently developed symptomatic epiretinal membrane and underwent 25G PPV/MP/ILM 2 months before presentation
Chief ocular complaint and duration of complaint
Persistent blurred vision and metamorphopsia noted initially 5 weeks after surgery, improved with steroid treatments, but frequently recurrent

Diagnosis
Chronic postsurgical posterior uveitis with macular edema OS
Previous treatments before YUTIQ
Short-duration intravitreal dexamethasone implants
Focal retinal photocoagulation
Steroid drops
YUTIQ treatment
OS only
Nine Months Follow-up After YUTIQ Treatment

Additional comments
No interval follow-up due to COVID-19; CME resolved with improvement in visual acuity
Will continue to monitor for late recurrence and potential need for retreatment with YUTIQ
Would like to obtain FA to evaluate for subclinical leakage in the context of a dry macula by OCT
![]()
Case Imagery
BCVA=best corrected visual acuity; CME=cystoid macular edema; FA=fluorescein angiography; ILM=internal limiting membrane; IOP=intraocular pressure; MP=macular pucker; OCT=optical coherence tomography; PPV=pars plana vitrectomy.